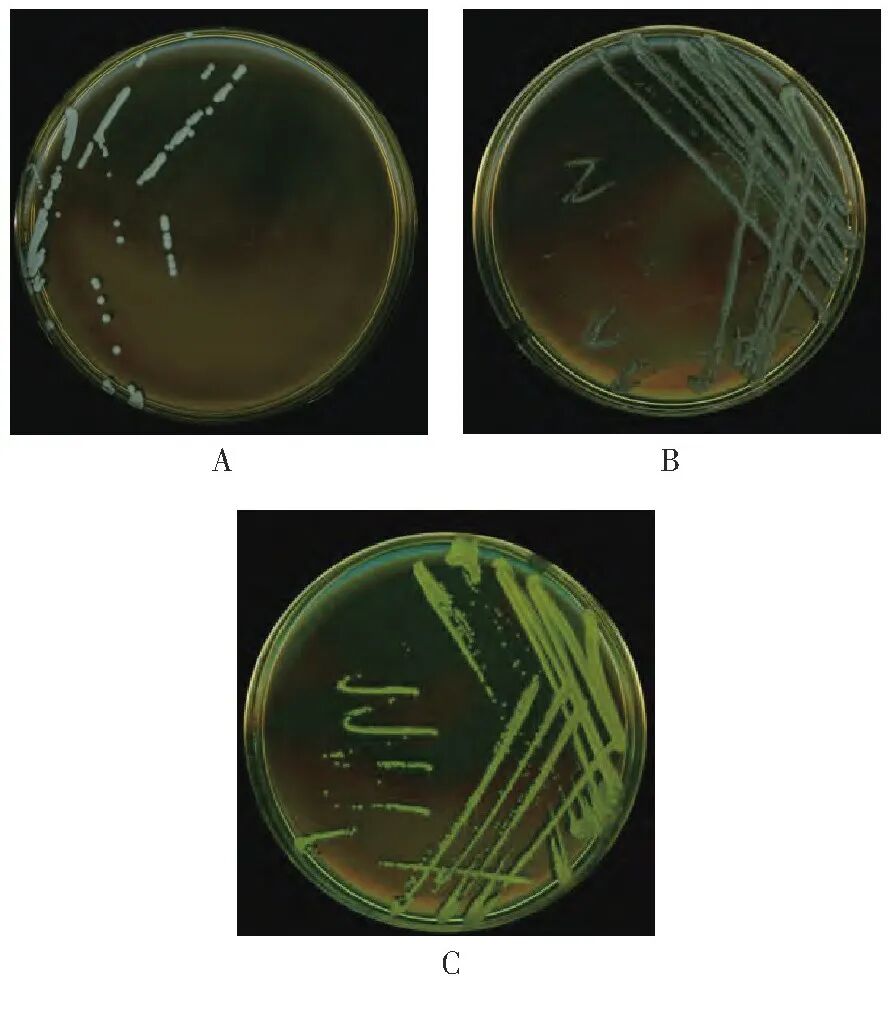

目的 研究制药企业洁净车间经臭氧消毒后微生物群落的组成及分布规律,分析臭氧消杀效果,为制药企业相同空间消毒方式提供数据参考。方法 采用基质辅助激光解吸电离飞行时间质谱(MALDI-TOF MS)技术和全自动微生物分析系统(VITEK®2Compact)鉴定方法,对收集的浮游菌和沉降菌进行鉴定分析。结果 776株菌均鉴定到属水平,消毒前427株菌,消毒后339株菌,A、B、C 3家企业减少比例分别为22%、19%和23%。消毒前后优势菌属均为葡萄球菌属、芽孢杆菌属、微球菌属,消毒效果最明显为微球菌属和考克菌属,消毒效果最差为芽孢杆菌属。其中人员更衣区污染菌量减少比例最少,企业B在消毒后的A级灌装区仍能采集到污染菌,说明臭氧消毒未完全覆盖可能出现的微生物污染风险结论 臭氧消毒是洁净车间空间消毒的常用方式,定期分析消毒后微生物种群,进一步提高消毒水平,保证药品生产有效性、安全性。
Part.00引 言
微生物污染是影响药品质量的重要因素,也是引发药品安全事故的重要原因[1]。目前,多数制药企业结合药品生产特性,多采用不同级别洁净车间来最大限度降低微生物、微粒和热原的污染,从而减少终产品的微生物污染。各国的药品生产质量管理规范和相关指导原则都对洁净车间提出较高要求[2-4],制药企业不仅需要建立完善的微生物环境监测计划,了解生产过程的微生物负载情况,更要掌握其污染微生物的分布、组成、来源,确立警戒限与纠偏限,以便对洁净区人员操作规程、清洁和消毒程序、设施设备的管理等生产全过程进行风险评估,保证洁净区处于正常的运行和良好的受控状态。
目前,制药企业对洁净车间污染微生物的研究大多停留在先根据培养特征进行分类,再通过几个基础生化反应试验检索微生物的所属范围,最后选择合适的生化试验条件将微生物鉴别到种[5],该方法操作繁琐、周期长,当药品受到微生物污染时,往往会出现溯源难、应变慢等问题。采用基质辅助激光解吸电离飞行时间质谱(matrix-assisted laser desorption ionization timeof-flight mass spectrometry,MALDI-TOF MS)或16S核糖体RNA(16S rRNA)基因测序方法,对表面蛋白或DNA进行检测,快速鉴定到微生物种或属,且对不常见的生化型及难培养的微生物等也有很好的鉴定能力,是近几年对大容量污染菌鉴定的主要技术手段,在复杂的菌种鉴定方面有广阔的应用前景[6-8]。
本研究对以臭氧为空间消毒的A、B、C 3家制药企业,按照《中国药典(2020年版)》四部要求进行采样,采用MALDI-TOF MS和全自动微生物分析系统(VITEK®2 Compact)对搜集的环境菌株进行鉴定。依据鉴定结果,统计3家制药企业环境菌的组成、数量、分布规律,分析臭氧消杀效果,为相同空间消毒方式制药企业提供数据参考。
Part.01材料与方法
1.1主要仪器
MALDI-TOF MS和VITEK®2 Compact全自动微生物分析系统购自法国生物梅里埃公司;DM500生物显微镜(德国Leica公司);二级生物安全柜(新加坡ESCO);CHP-9080型隔水式恒温培养箱(上海一恒科学仪器有限公司);STIK BI-450A型生化培养箱(施都凯仪器设备有限公司)。
1.2培养基与试剂
胰酪大豆胨琼脂(tryptic soytone agar,TSA)培养基(批号:221127)、沙氏葡萄糖琼脂(sabouraud dextrose agar,SDA)培养基(批号:220506)、革兰氏染色液(批号:221026)、霉菌染色液(批号:221206)均购自北京陆桥技术股份有限公司;VITEK®MS-α-氰基-4-羟基肉桂酸(α-Cyano-4-hydroxycinnamic acid,CHCA,批号:1009312950)、革兰氏阴性细菌鉴定卡(VITEK2 GN,批号:2412606503)、革兰氏阳性细菌鉴定卡(VITEK2 GP,批号:2422260503)、棒状杆菌鉴定卡(VITEK2CBC,批号:2462188203)、厌氧菌及棒状杆菌鉴定卡(VITEK2 ANC,批号:2442208503)及芽孢杆菌鉴定卡(VITEK2 BCL,批号:2392931203)均购自法国生物梅里埃公司。
1.3方法
1.3.1 采集与培养
企业A、B、C设定臭氧浓度均为20~30 mg/m3,其中A企业为大容量注射剂,平均环境温度为22℃,平均湿度为45%,洁净区分为A、C、D级,臭氧消毒时间为2 h,采集时间为2023年1月;B企业为小容量注射剂,平均环境温度为20℃,平均湿度为48%,洁净区分为A、B、C级,臭氧消毒时间为1 h,采集时间为2023年7月;C企业为原料药,平均环境温度为23℃,平均湿度为45%,洁净区均为D级,臭氧消毒时间为1.5 h,采集时间为2023年8月。
依据《医药工业洁净室(区)沉降菌的测试方法》(GB/T16294-2010)和《医药工业洁净室(区)浮游菌的测试方法》(GB/T 16293—2010)布置采样点,通过空气沉降和针孔式采样器进行样本采集,采集完成后将TSA平板倒置32.5℃培养箱中培养2~3 d。
1.3.2 分离与纯化
挑取TSA平板中菌落,分别进行2次以上TSA或SDA平板划线分离纯化。
1.3.3 微生物的鉴定
取分离纯化后的菌株,进行革兰氏染色或霉菌染色镜检,初步判断所得菌株类型后按照不同仪器要求进行菌种鉴定。
(1) VITEK®2 Compact法:依据革兰氏染色镜检结果选取相应鉴定卡,制备适宜浓度的菌悬液后进行鉴定。
(2) MALDI-TOF MS法:按照VITEK®MS标本准备流程,加样于靶点上,加入1µL CHCA基质液,室温自然挥干,干燥后放入MALDI-TOF MS仪器中,启动程序获取质谱图,将待测菌株与仪器数据库进行匹配,利用Myla软件进行查询。
Part.02结果
2.1环境菌的种类
(1)推动药材GAP的实施
对3家企业臭氧消毒前后进行浮游菌和沉降菌收集,共计766株菌,其中A企业消毒前收集108株菌,消毒后收集84株菌;B企业消毒前收集208株菌,消毒后收集169株菌;C企业消毒前收集111株菌,消毒后收集86株菌。对766株菌进行镜检染色,消毒前427株菌为24株真菌、265株G+球菌、37株G-球菌、59株G+杆菌、42株G-杆菌;消毒后收集339株菌为11株真菌、215株G+球菌、33株G-球菌、57株G+杆菌、23株G-杆菌。具体见图1。

图1 3家制药企业收集菌株形态特征统计图
2.2环境菌的分离纯化
(1)提取工艺优化
对收集的环境菌分别进行传代,并同时进行镜检,使用纷腾H9扫描仪,采用RGB模式,分辨率600 ppi,对2~4代进行1∶1扫描。图2结果显示,部分分离的菌落形态特征有明显变化,如某株环境菌2代菌落颜色为白色,革兰氏染色为阳性球菌;3代菌落为淡黄色,革兰氏染色为阳性球菌;4代菌落颜色为金黄色,革兰氏染色为阳性球菌。对2、3、4代菌落分别经MALDI-TOF MS鉴定均为藤黄微球菌,菌落典型特征应呈金黄色。因此,对收集的环境菌进行传代不仅可以达到分离纯化的目的,也有利于环境菌典型特征恢复。
注:A.2代;B.3代;C.4代。
图2 菌株扫描图
2.3菌株鉴定结果
对搜集到776株菌,经MALDI-TOF MS和VITEK®2 Compact鉴定到属水平占比100%,对臭氧消毒前后进行数据统计分析,具体见图3。消毒前后占比数量最多的优势菌属为葡萄球菌属、芽孢杆菌属、微球菌属,臭氧消毒后占比提高的为芽孢杆菌属,其余菌属均有所下降,占比下降最多的为微球菌属和考克菌属。

图3 3家制药企业洁净车间臭氧消毒前后微生物群落组成图
注:A.消毒前;B.消毒后。
统计臭氧消毒后3种优势菌属的菌种类别可得,企业A葡萄球菌属鉴定到属水平为42株,最多的是表皮葡萄球菌和人葡萄球菌,均为14株;芽孢杆菌属鉴定到属水平为14株,最多的是枯草芽孢杆菌,为3株;微球菌属鉴定到属水平为4株,均为藤黄微球菌。企业B葡萄球菌属鉴定到属水平为42株,最多的是人葡萄球菌和表皮葡萄球菌,分别为13株和11株;芽孢杆菌属鉴定到属水平为24株,最多的是高度/短小芽孢杆菌和蜡样芽孢杆菌,分别为11株和4株;微球菌属鉴定到属水平为35株,最多的是藤黄微球菌,为30株。企业C葡萄球菌属鉴定到属水平为40株,最多的是腐生葡萄球菌,为30株;芽孢杆菌属鉴定到属水平为7株,最多的是蜡样芽孢杆菌,为3株;微球菌属鉴定到属水平为4株,均为藤黄微球菌,具体见图4。

图4 臭氧消毒后葡萄球菌属、芽孢杆菌属、微球菌属的菌株分布
2.4臭氧消毒前后菌株的分布情况
按照不同洁净级别统计3家制药企业臭氧消毒前后菌株的分布情况,企业A中在人员更衣区、缓冲区、核心生产区(C级)消毒后环境污染菌减少比例最少,其中人员更衣区(D级)消毒后检出环境污染菌多于消毒前;企业B中人员更衣区(B、C级)、缓冲区、卫生清洁区(C级)消毒后环境污染菌减少比例最少;企业C中人员更衣区、缓冲区、核心生产区(D级)消毒后环境污染菌减少比例最少。3家制药企业臭氧消毒前后菌株分布情况详见表1~表3。
表1 企业A臭氧消毒前后菌株的分布情况

表2 企业B臭氧消毒前后分布情况

表3 企业C臭氧消毒前后分布情况

Part.03讨论
3.1采集样本的代表性
本研究选取的3家制药企业均符合药品生产质量管理规范生产车间要求,洁净分区明确,处于同一地域,洁净车间温湿度基本一致,在不同采集时间,对臭氧消毒前进行全面采集,是为了尽可能多地采集环境污染菌种类和数量,收集菌株具有一定的代表性;臭氧消毒浓度基本一致,对臭氧消毒后进行全面采集,是为了研究在不同条件(包括消毒时间、生产工艺、药品种类)下臭氧的消杀效力,评价臭氧消毒效率,使得出的结论更具有客观性。微生物鉴定方法选择MALDI-TOF MS和VITEK®2 Compact,利用鉴定不同原理,不同数据库,相互验证鉴定结果,准确率高,鉴定结果可靠。
3.2环境菌分离和纯化
本研究收集的臭氧消毒后菌株因受到长期低营养、化学消毒剂的作用等因素的影响,代谢活动被抑制,部分菌株不呈典型菌落形态特征,生化反应不典型,分离划线需要延长培养时间或更换培养条件,如使用血平板或兼性厌氧条件,对环境菌的选择和鉴定有较大影响。需要检验人员具备科学的判断,优化培养条件,尽量恢复环境菌典型特征,避免有漏检、错检的环境微生物存在。
此外,进行2次以上TSA平板划线后,对培养皿菌落颜色、形状、边缘、光泽等形态特征进行判定,对培养特征一致的培养皿,挑取不同菌落进行MALDI-TOF-MS和VITEK®2 Compact鉴定,有的为相同属、不同种,如溶血葡萄球菌和沃氏葡萄球菌,有的为相同科、不同属,如溶酪巨球菌和人葡萄球菌。因此,仅凭培养特征判定是否已经达到分离纯化目的是不可靠的,还需要有适当的鉴定,判定是否需要继续传代纯化,保证鉴定结果准确性。
3.3洁净区污染源分析
消毒前共收集427株污染环境菌,数量最多的为葡萄球菌属,这类菌株常附殖于人的眼、鼻、口、耳、喉、头和手[9-10],从事药品生产的人员由于消毒不彻底、动作幅度过大、缺乏无菌操作意识等原因,带入人源性污染。高抗性芽孢杆菌属和曲霉菌属广泛分布于空气、土壤和水中,是自然界常见微生物之一[11],主要存在于物料与包材中,属于因灭菌不彻底引入的污染。微球菌属污染最多的是藤黄微球菌,占80%以上,该菌同葡萄球菌属主要来源洁净区工作人员。不动杆菌属是检出最多革兰氏阴性菌,该类微生物在皮肤和物料上均有检出,因粘附力极强,可能成为贮菌源[12],造成同一区域多次检出,应加强对该菌属的污染控制,防止扩散。
3.4臭氧消杀效果分析
臭氧是一种强氧化性气体,具有高效、广谱、无二次污染、杀菌彻底等优点,是常用的空间消毒剂[13]。3家制药企业臭氧消毒时间均不少于30 min,都是在消毒换气后立即进行全面采样。根据研究可得,臭氧消毒后共收集339株菌,A、B、C 3家制药企业洁净车间内污染菌减少比例分别为22%、19%和23%。消毒前后优势菌属均为葡萄球菌属、芽孢杆菌属、微球菌属,消毒效果最明显为微球菌属和考克菌属,消毒效果最差为芽孢杆菌属。其中人员更衣区污染菌量减少比例最少,企业B在消毒后的A级灌装区仍能采集到污染菌,说明臭氧消毒未完全覆盖可能出现的微生物污染风险,企业应积极分析影响因素,优化消毒条件、联合使用紫外线照射或过氧化氢发生器等手段,提高臭氧消毒效力,或将臭氧消毒后出现频次高、难杀灭的菌种纳入表面消毒剂验证范围,进一步提高消杀效果,保证药品生产有效性、安全性。
3.5臭氧消杀效果影响因素分析
根据调研,洁净车间在臭氧消毒时有以下情况:(1)因设施设备影响部分区域面积大且距离臭氧发生端远,无法全部维持高浓度消毒剂量;(2)消毒前污染微生物数量多、种类多,各种微生物因生物结构不同,臭氧对其消杀效果也不同;(3)污染微生物负载量大的区域,具有团聚的趋势,消毒时会有类似臭氧抗性的效果[14];(4)通常洁净车间的相对湿度控制在45%~65%,小于标准规定的大于等于70%要求[15],会影响臭氧消毒器的消毒效果;(5)缺乏对消毒时间的验证。
综上所述,制药企业洁净车间的环境控制是一项长期艰巨的任务,建立微生物数据库,科学分析每一项管理措施,验证合理有效的清洁消毒方式,最大程度减少微生物污染的可能性,使产品的质量处于持续稳定的发展方向。
参考文献
1 刘亚茹 , 余萌 , 肖璜 , 等 . 五家制药企业洁净区微生物群落分 析 [J]. 中国药事 , 2019, 33(7): 796-802. [Liu YR, Yu M, Xiao H, et al. Analysis of microfora in clean areas of five pharmaceutical enterprises[J]. Chinese Pharmaceutical Affairs, 2019, 33(7): 796- 802.] DOI: 10.16153/j.1002-7777.2019.07.012.
2 U.S. Food and Drug Administration. Guidance for industry: sterile drug productsproducedbyasepticprocessing-currentgoodmanufacturingpractice[EB/OL]. (2004-09-01) [2024-12-05]. http://www.fda.gov/media/71026/download.
3 European Commission. EU guideline to good manufacturing practice medicinal products for human and veterinary use. Annex 1: manufacture of sterile medicinal products (The second targeted consultation) [EB/OL]. (2020-02-20) [2024-12-05]. https:// ec.europa.eu/ health/sites/health/ files/files/ gmp/2020_annex1ps_ sterile_medicinal_products_en.pdf.
4 Pharmaceuticals and Medical Devices Agency. Guidance on the manufacture of sterile pharmaceutical products by aseptic processing[EB/OL]. (2011-04-01) [2024-12-05]. http://www. pmda. go.jp/ files/000153543.pdf.
5 中国药典 2020 年版 . 四部 [S]. 2020: 503-506.
6 郭 琦 . 基 于 VITEK MS 及 VITEK2 Compact 的 更 年 宁 微 生 物 污 染 调 查 [J]. 中 成 药 , 2024, 46(10): 3523-3528. [Guo Q. Investigation of microbial pollution in geng nian ning based on VITEK MS and VITEK2 compact[J]. Chinese Traditional Patent Medicine, 2024, 46(10): 3523-3528.] DOI: 10.3969/ j.issn.1001-1528.2024.10.057.
7 宋明辉 , 李琼琼 , 秦峰 , 等 . 无菌药品生产企业过程污染 微生物菌株库的建立及数据分析 [J]. 药物分析杂志 , 2019, 39(11): 1954-1960. [Song MH, Li QQ, Qin F, et al. Establishment and data analysis of a contaminated microorganisms library for sterile pharmaceutical production processes[J]. Chinese Journal of Pharmaceutical Analysis, 2019, 39(11): 1954-1960.] DOI: 10.16155/j.0254-1793.2019.11.05.
8 郑小玲 , 王征南 , 王知坚 , 等 . 药品微生物检测实验室环 境菌库的建立 [J]. 中国现代应用药学 , 2015, 32(7): 847- 850. [Zheng XL, Wang ZN, Wang ZJ, et al. Establishment of the environmentally microbial library in the drug sterility testing laboratory[J]. Chinese Journal of Modern Applied Pharmacy, 2015, 32(7): 847-850.] DOI: 10.13748/j.cnki.issn1007-7693.2015.07.019.
9 甘永琦 , 阮斌 , 零文超 , 等 . 药品企业生产车间洁净环境沉降菌的鉴定分析 [J]. 药物分析杂志 , 2020, 40(9): 1684-1691. [Gan YQ, Ruan B, Ling WC, et al. Identification and analysis of sedimentary bacteria of clean environment of production workshop in pharmaceutical manufacturers[J]. Chinese Journal of Pharmaceutical Analysis, 2020, 40(9): 1684-1691.] DOI: 10.16155/j.0254-1793. 2020. 09.21.
10 李南 , 孙丽媛 , 关奕泽 , 等 . 药物生产车间污染微生物的快速鉴定和污染微生物资源及信息库的建立 [J]. 药物分析杂志 , 2021, 41(3): 474-483. [Li N, Sun LY, Guan YZ, et al. Rapid identification of contaminated microorganisms in drug production work area and establishment of contaminated microorganism resource bank and database[J]. Chinese Journal of Pharmaceutical Analysis, 2021, 41(3): 474-483.] DOI: 10.16155/j.0254-1793.2021.03.13.
11 Sandle T. A review of clean room microflora: types, trends, and patterns[J]. PDA J Pharm Sci Technol, 2011, 65(4): 392-403. DOI: 10.5731/pdajpst 2011.00765.
12 张弛 , 张建玲 , 薛梅 , 等 . 制药企业 CNC 区域微生物数据库的建立及微生物种群分析 [J]. 中国生物制品学杂志 , 2023, 36(12): 1503-1514. [Zhang C, Zhang JL, Xue M, et al. Establishment of CNC regional microbial database and microbia population analysis for pharmaceutical enterprises[J]. Chinese Journal of Biologicals, 2023, 36(12): 1503-1514.] DOl: 10.13200/j.cnki.cjb.000082.
13 曹越 , 帖金凤 , 晁思琪 , 等 . 一种新型板式臭氧消毒机对空气及物体表面消毒效果研究 [J]. 中国消毒学杂志 , 2024, 41(3): 179-182. [Cao Y, Tie JF, Zhao SQ, et al. Study on disinfection effect of a novel plate ozone disinfector on air and object surface[J]. Chinese Journal of Disinfection, 2024, 41(3): 179-182.]DOI: 10.11726/j.issn.1001-7658.2024.03.006.
14 张彭义 , 李惠南 , 杨洁 , 等 . 臭氧用于空气和表面消毒的研究进展 [J]. 安全与环境学报 , 2021, 21(3): 1277-1291. [Zhang PY, Li HN, Yang J, et al. Research progress on ozone for air and surface disinfection[J]. Journal of Safety and Environment, 2021, 21(3): 1277-1291.] DOI: 10.13637/j.issn.1009-6094.2020.0848.
15 国家市场监督管理总局 , 国家标准化管理委员会 . 臭氧消毒器卫生要求 . GB28232-2020[S]. 2020.
邵丽竹
何发
无菌制剂生产作为制药工业的核心关键环节,直接关乎药品的安全性与有效性。为应对无菌生产面临的极高技术挑战以及不断更新的法规要求,2025(第十七届)弗戈制药工程国际论坛特别设立分论坛1——“无菌制剂生产”。
2025-09-08 本网编辑
为促进制药行业前沿探索与高质量发展,推动核心技术共享与创新实践传播,《流程工业》制药工艺与装备期刊现面向制药行业征集高质量稿件。
2025-09-04 本网编辑
2025-11-25
2025-11-25
2025-11-18
2025-11-19
2025-11-17
2025-11-21
2025-11-18
本文以某制药产线的灌装机设备为研究对象,采用计算流体动力学(CFD)仿真技术对充氮装置的充氮性能进行分析,并结合分析结果对氮幕结构进行了优化设计。随后,针对优化方案进行性能仿真验证,结果显示优化后的顶空残氧量降低至0.252%。为了进一步验证优化方案的实际效果,将优化方案应用于实际产线进行性能测试,测得的顶空残氧量为0.68%,这一结果满足了小于1%的要求,表明其充氮保护性能已达到国际先进水平。
作者:王志刚、刘依宽、刘佳鑫
评论
加载更多